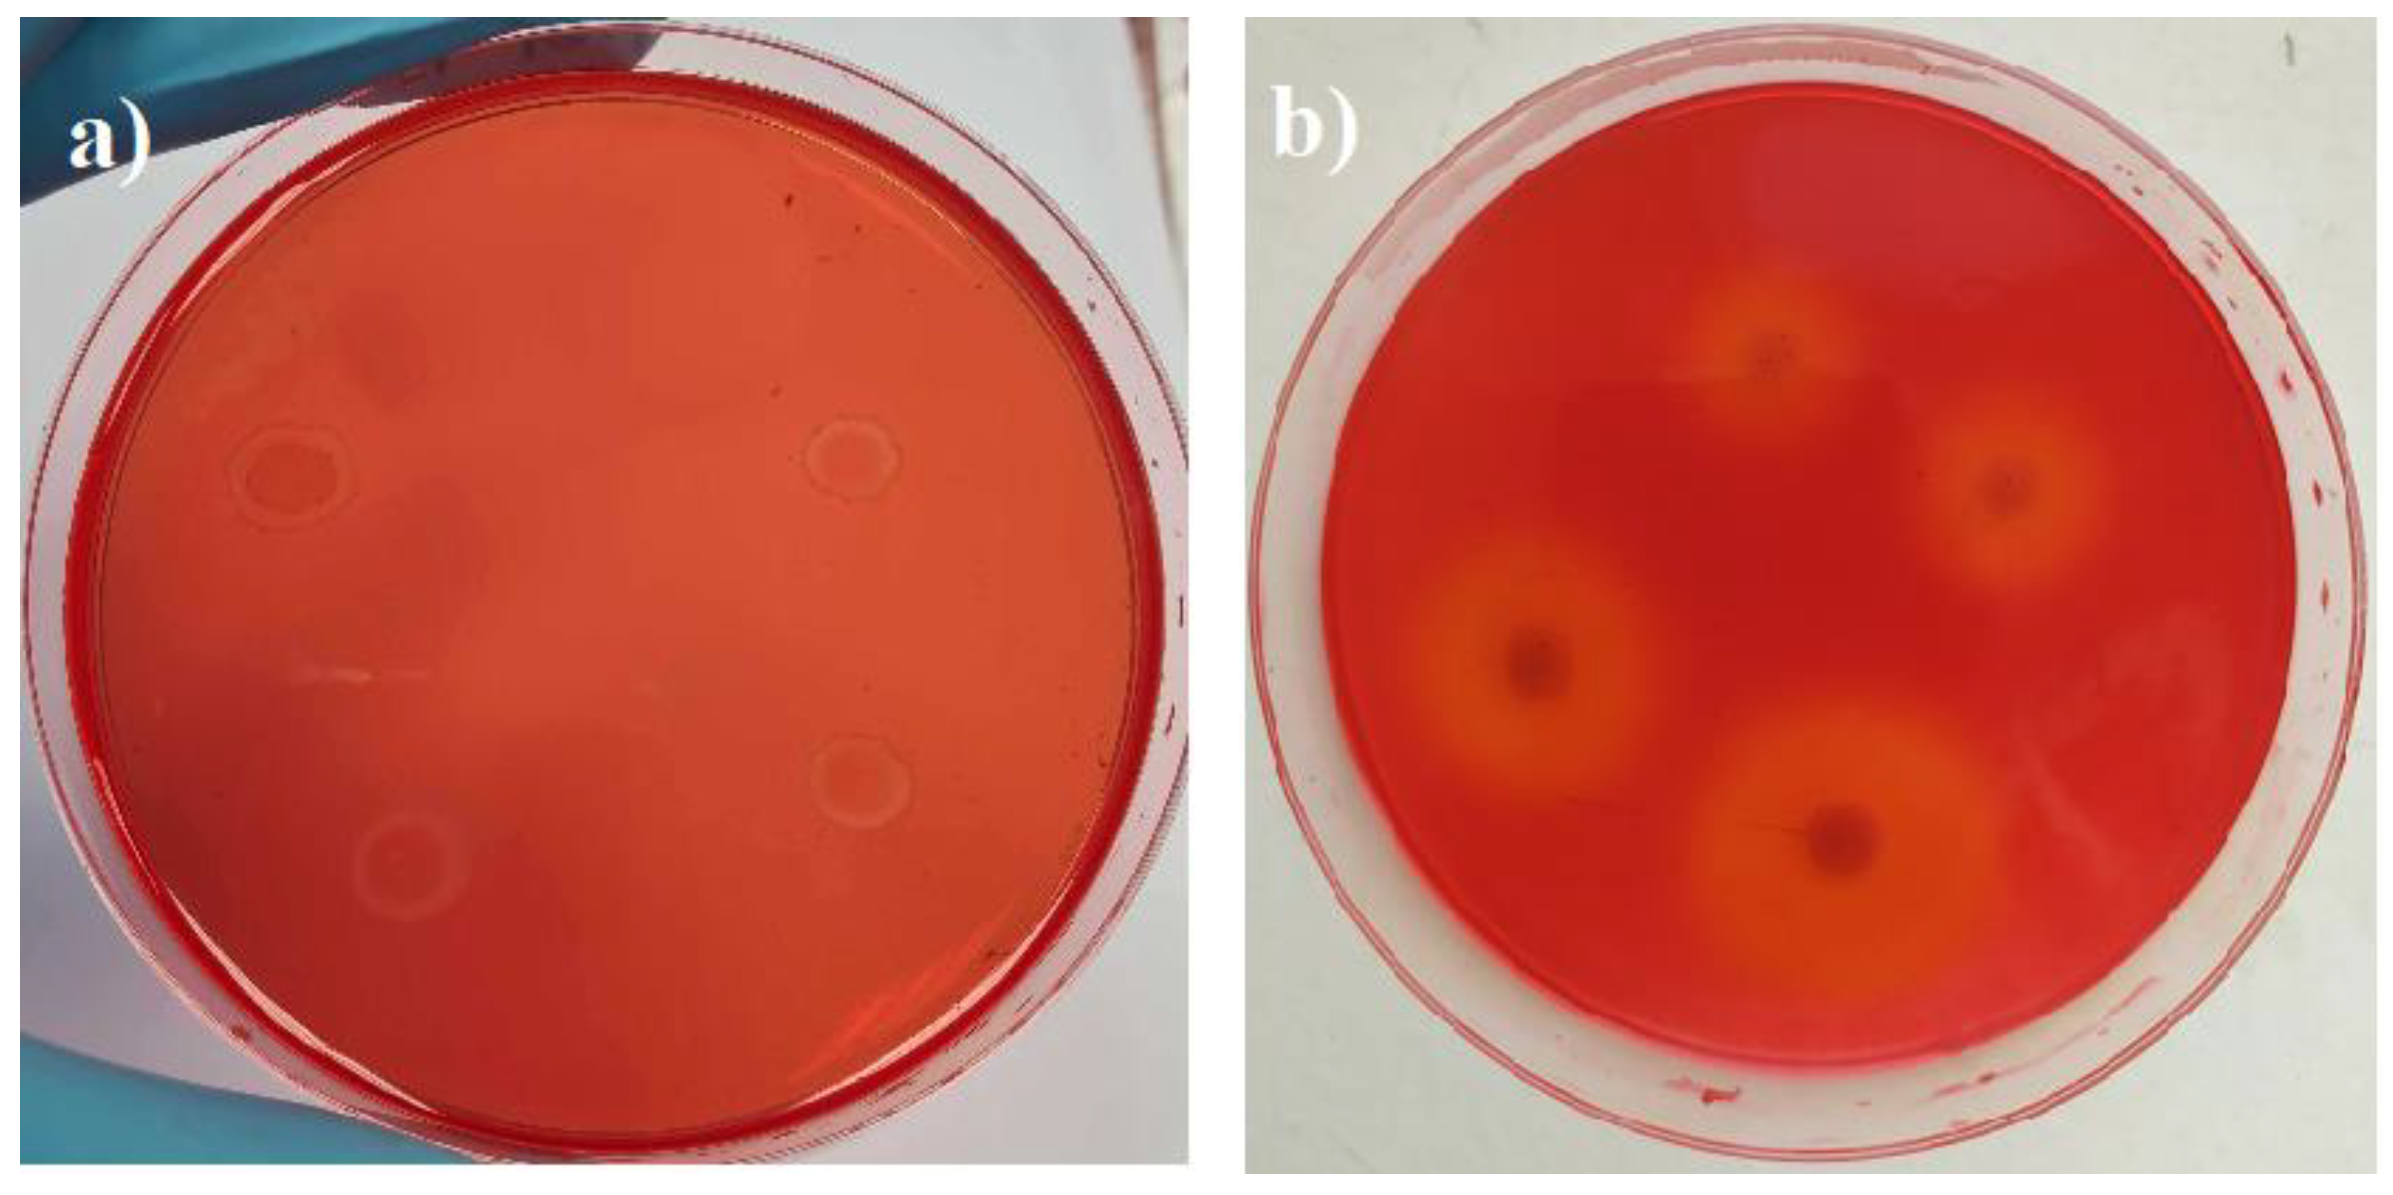
Microorganisms 11 00477 g002

The Impact of Microorganisms on the Performance of Linseed Oil and Tung Tree Oil Impregnated Composites Made of Hemp Shives and Corn Starch
Abstract
:1. Introduction
2. Materials and Methods
2.1. Materials
2.2. Preparation of HS- and CS-Based Biocomposites and Their Incubation with Microorganisms
2.3. Test Methods
2.3.1. Enzyme Activity Assays
2.3.2. Structural and Physic-Mechanical Tests
3. Results and Discussion
3.1. Enzymatic Activities and Microstructure of HS- and CS-Based Biocomposites That Were Impregnated with Different Oils
3.2. Density and Thermal Conductivity of Biocomposites before and after Impact of Microorganisms
3.3. Water Absorption and Compressive Strength Properties of Biocomposites before and after the Impact of Microorganisms
4. Conclusions
Author Contributions
Funding
Institutional Review Board Statement
Informed Consent Statement
Data Availability Statement
Conflicts of Interest
References
- Ozdemir, T.; Temiz, A.; Aydin, I. Effect of wood preservatives on surface properties of coated wood. Adv. Mater. Sci. Eng. 2015, 2015, 631835. [Google Scholar] [CrossRef]
- Alorbu, C.; Cai, L. Fungal resistance and leachability of genipin-crosslinked chitosan treated wood. Int. Biodeterior. Biodegrad. 2022, 169, 105378. [Google Scholar] [CrossRef]
- Spear, M.J.; Curling, S.F.; Dimitriou, A.; Ormondroyd, G.A. Review of Functional Treatments for Modified Wood. Coatings 2021, 11, 327. [Google Scholar] [CrossRef]
- Evans, P.D.; Matsunaga, H.; Preston, A.F.; Kewish, C.M. Wood Protection for Carbon Sequestration—A Review of Existing Approaches and Future Directions. Curr. For. Rep. 2022, 8, 181–198. [Google Scholar] [CrossRef]
- Woźniak, M. Antifungal Agents in Wood Protection—A Review. Molecules 2022, 27, 6392. [Google Scholar] [CrossRef] [PubMed]
- Zelinka, S.L.; Altgen, M.; Emmerich, L.; Guigo, N.; Keplinger, T.; Kymäläinen, M.; Thybring, E.E.; Thygesen, L.G. Review of Wood Modification and Wood Functionalization Technologies. Forests 2022, 13, 1004. [Google Scholar] [CrossRef]
- Mishra, P.K.; Singh, P.; Prakash, B.; Kedia, A.; Dubey, N.K.; Chanotiya, C.S. Assessing essential oil components as plant-based preservatives against fungi that deteriorate herbal raw materials. Int. Biodeterior. Biodegrad. 2013, 80, 16–21. [Google Scholar] [CrossRef]
- Singh, A.; Dwivedy, A.K.; Singh, V.K.; Upadhyay, N.; Chaudhari, A.K.; Das, S.; Dubey, N.K. Essential oils based formulations as safe preservatives for stored plant masticatories against fungal and mycotoxin contamination: A review. Biocatal. Agric. Biotechnol. 2018, 17, 313–317. [Google Scholar] [CrossRef]
- Tascioglu, C.; Yalcin, M.; Sen, S.; Akcay, C. Antifungal properties of some plant extracts used as wood preservatives. Int. Biodeterior. Biodegrad. 2013, 85, 23–28. [Google Scholar] [CrossRef]
- Hassan, E.B.; El-Giar, E.M.; Steele, P. Evaluation of the antioxidant activities of different bio-oils and their phenolic distilled fractions for wood preservation. Int. Biodeterior. Biodegrad. 2016, 110, 121–128. [Google Scholar] [CrossRef]
- Bi, Z.; Zhao, Y.; Morrell, J.J.; Lei, Y.; Yan, L. The antifungal mechanism of konjac flying powder extract and its active compounds against wood decay fungi. Ind. Crops Prod. 2021, 164, 113406. [Google Scholar] [CrossRef]
- Tang, C.C.; Li, Y.; Kurnaz, L.B.; Li, J. Development of eco-friendly antifungal coatings by curing natural seed oils on wood. Prog. Org. Coat. 2021, 161, 106512. [Google Scholar] [CrossRef]
- Chalapud, M.C.; Herdt, M.; Nicolao, E.S.; Ruseckaite, R.A.; Ciannamea, E.M.; Stefani, P.M. Biobased particleboards based on rice husk and soy proteins: Effect of the impregnation with tung oil on the physical and mechanical behavior. Constr. Build. Mater. 2020, 230, 116996. [Google Scholar] [CrossRef]
- Janesch, J.; Arminger, B.; Gindl-Altmutter, W.; Hasmann, C. Superhydrophobic coatings on wood made of plant oil and natural wax. Prog. Org. Coat. 2020, 148, 105891. [Google Scholar] [CrossRef]
- Arminger, B.; Jaxel, J.; Bacher, M.; Gindl-Altmutter, W.; Hasmann, C. On the drying behavior of natural oils used for solid wood finishing. Prog. Org. Coat. 2020, 148, 105831. [Google Scholar] [CrossRef]
- Vasiliauskienė, D.; Balčiūnas, G.; Boris, R.; Kairytė, A.; Kremensas, A.; Urbonavičius, J. The Effect of Different Plant Oil Impregnation and Hardening Temperatures on Physical-Mechanical Properties of Modified Biocomposite Boards Made of Hemp Shives and Corn Starch. Materials 2020, 13, 5275. [Google Scholar] [CrossRef]
- Vasiliauskienė, D. Effect of Microorganisms on the Physical and Mechanical Properties and Biodecay of Cellulose-Based Materials, 1st ed.; Ciklonas: Vilnius, Lithuania, 2022; p. 128. [Google Scholar]
- Zhao, J.; Ma, M.; Seng, Z.; Yu, P.; Gong, D.; Deng, S. Production, purification and biochemical characterisation of a novel lipase from a newly identified lipolytic bacterium Staphylococcus caprae NCU S6. J. Enzyme Inhib. Med. Chem. 2021, 36, 249–257. [Google Scholar] [CrossRef]
- EN 1602; Thermal Insulating Products for Building Applications—Determination of the Apparent Density. European Standardization Committee: Brussels, Belgium, 2013.
- EN 826; Thermal Insulating Products for Building Applications—Determination of Compression Behavior. European Standardization Committee: Brussels, Belgium, 2013.
- EN ISO 29767; Thermal Insulating Products for Building Applications—Determination of Short-Term Water Absorption by Partial Immersion. European Standardization Committee: Brussels, Belgium, 2019.
- EN 317; Particleboards and Fibreboards—Determinations of Swelling in Thickness after Immersion in Water. European Standardization Committee: Brussels, Belgium, 1999.
- EN 325; Wood-Based Panels—Determination of Dimensions of Test Pieces. European Standardization Committee: Brussels, Belgium, 2012.
- EN 12667; Thermal Performance of Building Materials and Products—Determination of Thermal Resistance by Means of Guarded Hot Plate and Heat Flow Meter Methods. European Standardization Committee: Brussels, Belgium, 2002.
- Khoirunnisa, S.A.; Oetari, A.; Sjamsuridzal, W. Carboxymethyl cellulose (CMC)-degrading ability of Rhizopus azygosporus UICC 539 at various temperatures. AIP Conf. Proc. 2020, 050024, 1–7. [Google Scholar]
- Liang, Y.-L.; Zhang, Z.; Wu, M.; Wu, Y.; Feng, J.-X. Isolation, Screening, and Identification of Cellulolytic Bacteria from Natural Reserves in the Subtropical Region of China and Optimization of Cellulase Production by Paenibacillus terrae ME27-1. Biomed Res. Int. 2014, 2014, 512497. [Google Scholar] [CrossRef]
- Nykter, M.; Kymäläinen, H.-R.; Thomsen, A.B.; Lilholt, H.; Koponen, H.; Sjöberg, A.-M.; Thygesen, A. Effects of thermal and enzymatic treatments and harvesting time on the microbial quality and chemical composition of fibre hemp (Cannabis sativa L.). Biomass Bioenerg. 2008, 32, 392–399. [Google Scholar] [CrossRef]
- Behera, B.C.; Sethi, B.K.; Mishra, R.R.; Dutta, S.K.; Thatoi, H.N. Microbial cellulases—Diversity & biotechnology with reference to mangrove environment: A review. J. Genet. Eng. Biotechnol. 2017, 15, 197–210. [Google Scholar] [PubMed]
- Hegyi, A.; Vermeşan, H.; Lăzărescu, A.-V.; Petcu, C.; Bulacu, C. Thermal Insulation Mattresses Based on Textile Waste and Recycled Plastic Waste Fibres, Integrating Natural Fibres of Vegetable or Animal Origin. Materials 2022, 15, 1348. [Google Scholar] [CrossRef] [PubMed]
- Battaglia, E.; Benoit, I.; Brink, J.; Wiebenga, A.; Coutinho, P.M.; Henrissat, B.; Vries, R.P. Carbohydrate-active enzymes from the zygomycete fungus Rhizopus oryzae: A highly specialized approach to carbohydrate degradation depicted at genome level. BMC Genom. 2011, 12, 38. [Google Scholar] [CrossRef] [PubMed]
- Clayton, E.E.; Smith, T.E.; Shaw, K.J.; Gaines, J.G.; Graham, T.W.; Yeager, C.C. Fungicidal tests on blue mold (Peronospora tabacina) of tobacco. J. Agric. Res. 1943, 66, 261–276. [Google Scholar]
- Breiing, V.; Hillmer, J.; Schmidt, C.; Petry, M.; Behrends, B.; Steiner, U.; Kraska, T.; Pude, R. Fungicidal efficacy of drying plant oils in green beans against bean rust (Uromyces appendiculatus). Plants 2021, 10, 143. [Google Scholar] [CrossRef]
- Piškur, B.; Zule, J.; Piškur, M.; Jurc, D.; Pohleven, F. Fungal wood decay in the presence of fly ash as indicated by gravimetrics and by extractability of low molecular weight volatile organic acids. Int. Biodeterior. Biodegrad. 2009, 63, 594–599. [Google Scholar] [CrossRef]
- Kwaśniewska-Sip, P.; Cofta, G.; Nowak, P.B. Resistance of fungal growth on Scots pine treated with caffeine. Int. Biodeterior. Biodegrad. 2018, 132, 178–184. [Google Scholar] [CrossRef]
- Shen, J. Advances in Wool Technology, 1st ed.; Woodhead Publishing Limited: Cambridge, UK, 2009; pp. 147–182. [Google Scholar]
- Tran-Ly, A.N.; Heeb, M.; Kalac, T.; Schwarze, F.W.M.R. Antimicrobial effect of fungal melanin in combination with plant oils for the treatment of wood. Front. Mater. 2022, 9, 915607. [Google Scholar] [CrossRef]
- Humar, M.; Lesar, B. Efficacy of linseed- and tung-oil-treated wood against wood-decay fungi and water uptake. Int. Biodeterior. Biodegrad. 2013, 85, 223–227. [Google Scholar] [CrossRef]
- He, Z.; Chapital, D.C.; Cheng, H.N.; Klasson, K.T.; Olanya, O.M.; Uknalis, J. Application of tung oil to improve adhesion strength and water resistance of cottonseed meal and protein adhesives on maple veneer. Ind. Crops Prod. 2014, 61, 398–402. [Google Scholar] [CrossRef]
- Shen, Z.; Kamdem, D.P. Antimicrobial activity of sugar beet lignocellulose films containing tung oil and cedarwood essential oil. Cellulose 2015, 22, 2703–2715. [Google Scholar] [CrossRef]
- Azizi-Lalabadi, M.; Hashemi, H.; Feng, J.; Jafari, S.M. Carbon nanomaterials against pathogens; the antimicrobial activity of carbon nanotubes, graphene/graphene oxide, fullerenes, and their nanocomposites. Adv. Colloid Interface Sci. 2020, 284, 102250. [Google Scholar] [CrossRef] [PubMed]
- Anosike-Francis, E.N.; Obianyo, I.I.; Salami, O.W.; Ihekweme, G.O.; Ofem, M.I.; Olorunnisola, A.O.; Azikiwe, P.O. Physical-Mechanical properties of wood based composite reinforced with recycled polypropylene and cowpea (Vigna unguiculata Walp.) husk. Clean. Mater. 2022, 5, 100101. [Google Scholar] [CrossRef]
- Martinez Lopez, Y.; Paes, J.B.; Gustave, D.; Gonçalves, F.G.; Méndez, F.C.; Nantet, A.C.T. Production of wood-plastic composites using cedrela odorata sawdust waste and recycled thermoplastics mixture from post-consumer products—A sustainable approach for cleaner production in Cuba. J. Clean. Prod. 2020, 244, 118723. [Google Scholar] [CrossRef]
- Johansson, P.; Ekstrand-Tobin, A.; Svensson, T.; Bok, G. Laboratory study to determine the critical moisture level for mould growth on building materials. Int. Biodeterior. Biodegrad. 2012, 73, 23–32. [Google Scholar] [CrossRef]
- Imken, A.A.P.; Brischke, C.; Kögel, S.; Krause, K.C.; Mai, C. Resistance of different wood-based materials against mould fungi: A comparison of methods. Eur. J. Wood Wood Prod. 2020, 78, 661–671. [Google Scholar] [CrossRef]
- Kord, B.; Ayrilmis, N.; Ghalehno, M.D. Effect of fungal degradation on technological properties of carbon nanotubes reinforced polypropylene/rice straw composites. Polym. Polym. Compos. 2021, 29, 303–310. [Google Scholar] [CrossRef]
- Lesar, B.; Humar, M. Use of wax emulsions for improvement of wood durability and sorption properties. Eur. J. Wood Wood Prod. 2011, 69, 231–238. [Google Scholar] [CrossRef]
- Nadali, E.; Karimi, A.; Tajvidi, M.; Naghdi, R. Natural Durability of a Bagasse Fiber/Polypropylene Composite Exposed to Rainbow Fungus (Coriolus versicolor). J. Reinf. Plast. Compos. 2010, 29, 1028–1037. [Google Scholar] [CrossRef]
- Mosiewicki, M.; Borrajo, J.; Aranguren, M.I. Mechanical properties of woodflour/linseed oil resin composites. Polym. Int. 2005, 54, 829–836. [Google Scholar] [CrossRef]
- Ashori, A.; Sheshmani, S.; Farhani, F. Preparation and characterization of bagasse/HDPE composites using multi-walled carbon nanotubes. Carbohyd. Polym. 2013, 92, 865–871. [Google Scholar] [CrossRef] [PubMed]

| Raw Materials | Biocomposite With Linseed Oil | Biocomposite with Tung Tree Oil |
|---|---|---|
| HS, g | 300 | |
| CS, g | 30 | |
| Boiling water, l | 2 | |
| EG wt.% by CS mass | 0 | 20 |
| FL, g/L | 30 | 0 |
| Linseed oil, % by biocomposite mass | 63.4 | 0 |
| Tung tree oil, % by biocomposite mass | 0 | 85.5 |
Disclaimer/Publisher’s Note: The statements, opinions and data contained in all publications are solely those of the individual author(s) and contributor(s) and not of MDPI and/or the editor(s). MDPI and/or the editor(s) disclaim responsibility for any injury to people or property resulting from any ideas, methods, instructions or products referred to in the content. |
© 2023 by the authors. Licensee MDPI, Basel, Switzerland. This article is an open access article distributed under the terms and conditions of the Creative Commons Attribution (CC BY) license (https://creativecommons.org/licenses/by/4.0/).
Share and Cite
Vasiliauskienė, D.; Balčiūnas, G.; Boris, R.; Kairytė, A.; Urbonavičius, J. The Impact of Microorganisms on the Performance of Linseed Oil and Tung Tree Oil Impregnated Composites Made of Hemp Shives and Corn Starch. Microorganisms 2023, 11, 477. https://doi.org/10.3390/microorganisms11020477
Vasiliauskienė D, Balčiūnas G, Boris R, Kairytė A, Urbonavičius J. The Impact of Microorganisms on the Performance of Linseed Oil and Tung Tree Oil Impregnated Composites Made of Hemp Shives and Corn Starch. Microorganisms. 2023; 11(2):477. https://doi.org/10.3390/microorganisms11020477
Chicago/Turabian StyleVasiliauskienė, Dovilė, Giedrius Balčiūnas, Renata Boris, Agnė Kairytė, and Jaunius Urbonavičius. 2023. "The Impact of Microorganisms on the Performance of Linseed Oil and Tung Tree Oil Impregnated Composites Made of Hemp Shives and Corn Starch" Microorganisms 11, no. 2: 477. https://doi.org/10.3390/microorganisms11020477







